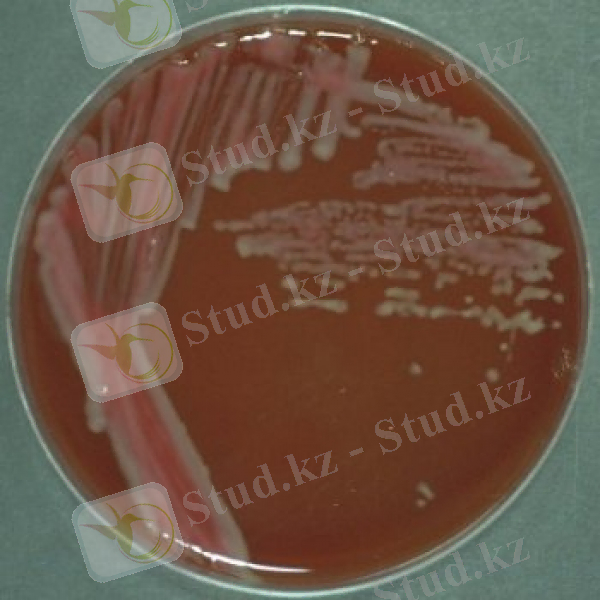
Campylobacter jejuni..jpg

Ірі қара малдағы кампилобактериоз: алдын алу, диагностика және емдеу әдістемесі


Ірі қара малдың кампилобактериоз ауруын алдын алу және емдеу
Мазмұны
Кіріспе . . . 5
І Сойып ашу хаттамасы . . . 6
1. 1 Хаттаманың кіріспе бөлімі . . . 6
1. 2 Өмірінің анамнезі . . . 6
1. 3 Ауруының анамнезі . . . 7
1. 4 Сыртқы өзгерістер . . . 7
1. 5 Ішкі тексеру . . . 8
1. 6 Патологиялық-анатомиялық балау . . . 8
1. 7 Зертханалық зерттеудің нәтижелері . . . 9
1. 8 Қорытынды . . . 9
1. 9 Жолдама (ілеспе) құжат . . . 10
II Әдебиетке шолу . . . 11
2. 1 Ірі қара малдың кампилобактериоз ауруы туралы мәлімет . . . 11
2. 2 Ірі қара малдың кампилобактериоз ауруының қоздырушысы . . . 11
2. 3 Ірі қара малдың кампилобактериоз ауруының эпиозоотологиялық мәліметтер . . . 13
2. 4 Ірі қара малдың кампилобактериоз ауруының өтуі мен белгілері . . . 14
2. 5 Ірі қара малдың кампилобактериоз ауруы кезінде өлекседегі патолого-анатомиялық белгілері . . . 15
2. 6 Ірі қара малдың кампилобактериоз ауруының балау әдістері . . . 15
2. 7 Ірі қара малдың кампилобактериоз ауруының алдын-алу шаралары . . . 19
Қорытынды . . . 21
Қосымша . . . 22
Қолданылған әдебиеттер тізімі . . . 23
Кіріспе
Курстық жұмыстың мақсаты - ірі қара малдардың кампилобактероз ауруы туралы мәлімет жинау, кампилобактериоз аурудан өлген малға сайып ашу хаттамасын толтыру, сонымен қатар өзіндік зерттеулерді жүргізу. Менің өзіндік зерттеуі ірі қара малдардың кампилобактериоз ауруын емдеудің өзіндік методикасын құрастыру. Методикасын құрастырып оны екі топқа бөліп, экономикалық тұрғыдан қандай емдеу тиімді болатындығын анытау.
Тақырыптың өзектілігі. Адамға және жануарларға ортақ аурулардан сақтау үшін біз осы антропозоонозды ауруларды білуіміз керек. Кампилобактериоз ауруы адамға да, жануарларға да, құстарға да қауіп төндіреді. Дүние жүзінде кампилобактериоз кең таралған. Осы ауруы көктем кезінде жиі кездеседі, өйткені жыныс жолдары арқылы таралады. Ал қоздырушының көзі жұққан өгіздер болып табылады. Сондықтан көктем кезінде қолдан ұрықтандыру станцияларында ветеринарлық санитарлық талаптарды қатаң ұстау керек. Кампилобактериоз ауру сиырды қысырлыққа апарады немесе аборт тудырады, сондықтан ол экономикалық зиянға әкеледі.
І Сойып ашу хаттамасы
1. 1 Хаттаманың кіріспе бөлімі
Хаттама № 9
Мал түрі - сиыр
Жынысы - әйел
Жасы - 3 жас
Түсі - қара
Салмағы - 250
Өлген күн - 24 сәуір 2017
Мал иесі - Серикпаев Т. Р.
Мал иесінің мекен-жайы - Қостанай облысы, Қамысты ауданы, Құдайқұл көшесі, 93 үй.
1. 2 Өмірінің анамнезі
Anamnez vitae - мал иесінің айту бойынша «Буренка» деген лақап атты сиыр шаруашылықта 2014 жылдан бері бар. Сиыр жыл бойына өрісте, жердегі шөппен азықтанады, ал қысқы уақытта қорада тұрады, қора бүкіл талаптарға сай жасалған. Үш мезгіл азықтанып отырылды. Сиырды азықтандыру рационы жалпы малдың ас қорыту жүйесінің ерекшелігін ескере отырып, оның сүйсініп жейтін жем-шөбінен құрастырылған. Азықтың құрамында сапасы сандық көрсеткіштерге сай келетін құрамында сиырдың организміне қажетті минералдық, витаминдік заттар болады. Сиырды уақытылы суарған. Суарудың қайнар көзі құдық. Жануарға қысқы мезгілде моцион жүргізілді. Жануарды моцинға жібермес бұрын, оны бір тексеріп алады.
1. 3 Ауруының анамнезі
Anamnez morbi - мал иесінің айтуы бойынша он алтысынан бастап ауру белгілері пайда болды.
Дененің температурасы көтерілді, тынышсыздық пайда болды, құйрығы көтеріп сиыр қисық (сгорбленный) тұрды. Қынаптың кілегей қабығын қан кернеп, ісініп ауырады, одан қанды сарысу ақты. Сиыр іш тастап, шуы түспеді. Аталып отырған аурумен жануар ертеректе ауырған жоқ. Шаруашылықта басқа малдар бұл аурумен ертеректе ауырмаған және ешқандай клиникалық белгілері байқалмаған. Жануарға ешқандай үйде емдеу жүргізілмеген.
Клиникалық диагноз - кампилобактериоз.
Сойып ашу жұмыстары 2017 жылы 24 сәуір күні сағат 10:00-де Қамысты ауданындағы ветеринарлық зертханада өткізілді.
Союды өткізген: ветеринарлық дәрігер Ысқақов М. Қ.
1. 4 Сыртқы өзгерістер
Сиыр өлексесін сыртқы өзгерістері бойынша зерттеу:
- Сиыр тұқымына жататын, қара түсті, қондылығы орташа келген, дене тұрқы дұрыс, салмағы
- Қынаптың кілегей қабығын қан кернеп, ісініп ауырып, одан қанды сарысу ақты.
- Сиыр іш тастап, шуы түспеді, жатырдың кілегей қабаты қабынып, қынаптан іріңді қалдықтар ақты.
- Сиыр орындарынан тұра алмады, сүтті аз ішті, самарқау.
1. 5 Ішкі тексеру
- Жатыр домбыққан, мүйізінде қабынудың ошақтары байқалған.
- Карункулдар үлкейген, шырынды, сұр түсті, қабынудың және некроздың ошақтар бар.
- Плацента домбыққан, ірімшік консистенциялы сары үлпешектермен жабылған.
- Түсік төлдің жеке тері учаскесінде домбығу, ал паренхиматозды мүшелерде қанталаулар болды.
- Төлдің терісінде шырышты іріңді массасы бар.
- Төлдің ұлтабарының массасы бүлдыр, сұр-ақ үлпершектермен қоңыр түсті.
- Төлдің бөлігі мумифицирленген.
1. 6 Патолого-анатомиялық балау
- Катаральді вагинит
- Қынаптың кілегей қабаттарының жіті гиперемия,
- Қан-шырышты ағулар,
- Эндометрит,
- Жатыр домбыққан.
1. 7 Зертханалық зерттеулердің нәтижелері
Зертханалық зерттеу Қостанай облысы, Қамысты ауданындағы зертханада өткізілді. Зертханаға өлген жануардың жатырдан аққан шырышты, сонымен қатар абборталған тұтас төлді, плацентасы жіберілген. Бактериологиялық зерттеу жүргізіліп, нәтижесі өң болып шықты.
1. 8 Қорытынды
Зертханалық зерттеу нәтижесінің қорытынды бойынша аурудың клиникалық суреті және ашып сою нәтижесі бойынша кампилобактериоз ауруына балау қойылды. Өлімге ұшырауының негізгі себебі кампилобактероз бактериясы малдың жатырына еніп, қабыну процесін тудырды, сонымен қатар қанның плацентарлы циркуляция бұзылудың нәтижесінде аборт пайда болды. Жатыр мойында қанталау нәтижесінде шырыш қанмен бірге ағып, вагинит пайда болды. Мал аборттан кейін әлсіреп өлді.
24. 02. 2017 жыл
Жолдама (ілеспе) құжат
Форма №3
Қамысты аудандық ветеринарлық лабораториясына
Мекен-жайы: Қамысты ауданы, Ленин көшесі, 49
Өлген сиырдың диагнозын анықтау мақсатында бағытталған.
Патологиялық материал (қандай, саны) : жатырдан аққан шырыш, абборталған тұтас төл, плацента жіберілді. Саны: 3.
Иесінің мекен-жайы (мал түрі, түсі) : Қостанай облысы, Қамысты ауданы, Құдайқұл көшесі, 93 үй.
Малдың түрі - сиыр, жасы - 3 жас.
Ауырған күні: 16 сәуір 2017 жылы
Өлген күні: 24 сәуір 2017 жылы
Аурудың клиникалық белгілері (сипаттамасы) : Дененің температурасы көтерілді, тынышсыздық пайда болды, құйрығы көтеріп сиыр қисық (сгорбленный) тұрды. Қынаптың кілегей қабығын қан кернеп, ісініп ауырады, одан қанды сарысу ақты. Сиыр іш тастады.
Патологоанатомиялық ашып сою кезіндегі деректер: Жатыр домбыққан, мүйізінде қабынудың ошақтары байқалған. Плацента домбыққан, ірімшік консистенциялы сары үлпешектермен жабылған. Түсік төлдің жеке тері учаскесінде домбығу, ал паренхиматозды мүшелерде қанталаулар болды.
Болжамды диагнозы (балауы) : кампилобактериоз ауруы
Пат. материалдың жіберген күні: 24. 05. 2017 ж
Лауазымы: ветеринариялық дәрігер Ысқақов М. Қ.
Қолы:
Студент: Аманжолова Д. А.
Иесі: Серикпаев Т. Р.
Ветеринарлық дәрігер: Ысқақов М. Қ.
II Әдебиетке шолу
2. 1 Ірі қара малдың кампилобактериоз ауруы туралы мәлімет
Кампилобактериоз (вибриоз) - көптеген жануарларда кездесетін, патогенді кампилобактериялары тудыратын, жыныс мүшелерін зақымдайтын зоонозды инфекциялық ауруы. Кампилобактериоз ауруымен адам да ауырады.
Тарихи мәлімет.
1918 жылы Америкада Смит және Тейлормен сиырдың виобирозды аборт табылды. КСРО-да кампилобактериоз бірінші рет В. Л. Якимов(1926) тапты. Клиникалық сипаттама және аурудың эпиозоотологиясын зерттеуді одан әрі П. А. Триленко, Е. В. Козловского, В. В. Павловского, В. К. Румянцова және т. б. аттарымен байланысты. Осы ауру көптеген елдерде анықталған.
2. 2 Ірі қара малдың кампилобактериоз ауруының қоздырушысы
Кампилобактериоз ауруының қоздырушысы Spirillaceae тұқымдастығының Campylobacter түріне жататын бактериясы. (Сурет 1) Кампилобактерияның 13 түрі белгілі. Кампилобактериялар ас қорыту жүйесінің камменсалдары болып барлық жылықанды жануарлардың түрлерінде жайылады. Кампилобактериялар (гр. campylo - бүгілген, bacter -таяқша) спираль немесе штопор тәрізді, грам теріс, спора түзбейтін, ұзындығы 0, 5-8, 0 мкм, диаметрі 0, 2-0, 8 мкм, белсенді қозғалатын полярлы орналасқан 1-2 қылаяқшасы бар бактериясы. Кокк тәрізді формасын тудыру мүмкін, әсіресе ескі культураларда.
Campylobacter түрінің бактериялары табиғатта кең таралған, барлық жануарлар түрлерінде, сонымен қатар адамда патогенді немесе патогенді емес штамм түрінде кездеседі.
Campylobacter fetus subspecies venerealis - ірі қара малдарда бедеулік және абортты шақыртатын облигатты паразит. Оны ауру сиырдың қынапта, өгіздің шәуетінде және препуциалды қапта, плацентасында және абортталған төлдердің ұлпаларында кездесуге болады.
Campylobacter fetus subspecies fetus - қой кампилобактериозы ауруының қоздырушысы. Сиырда, қашарда, мегежінде абортты тудырады. Әр түрлі мүшелерде және ұлпаларда орналасады. Оны ірі қара малдың, қойдың, шошқалардың және құстардың препуциясында, ұрық безінде, шәуетте, өт қабында, қанда, ішектің кілегейде және нәжісте бөлуге болады. Адамда безгекпен, бактериемиямен, түсік тастаумен, өт қабының қабынуымен, энтеритпен, эндокардит, менингоэнцефалитпен, септикалық артритпен, және басқа белгілермен белгіленетін генерализденген инфекциясын тудырады.
Campylobacter jejuni - ірі қара малдың, қойдың, жылқының, шошқаның, ешкінің, иттің, мысықтың, зертханалық және басқа жануарлардың ас қорыту жүйесінде орналасады. Оны ауру бұзаудан, сиыр-ананың қаннан, уыздан, қынап шырыштан бөлінеді. Ірі қара малда дезентериясын және абортты, ұй құстарда гепатитті, адамда, маймылда және мысықта жіті гастроэнтерит шақыртады.
Campylobacter sputorum, Campylobacter concisus және Campylobacter fecalis - ірі қара малдың, қойдың, жылқының және құстардың ас қорыту және жыныс жүйесінде кездеседі, бірақ жануарларға патогенді емес.

Сурет 1. Campylobacter fetus
Барлық кампилобактериялар 37°C температурада өседі. Бактерияларды бөлу және культивирлеу үшін келесі селективті орталарды қолданылады: темір-эритритті қанды агар, 0, 15-0, 2 % жартылай сұйық ет-бауырлы пептонды агар, 2-3% ет-бауырлы пептон агар. Культураларды Мартен агарда және майсыз Китта-Тароцци ортасында бөлуге де болады.
Көрінетін шоғырлар - жылтыр, тасырайған, сұр-інжу, себудан кейін 24-48 сағат өткеннен қоректік орталар тостағанында өседі. (Сурет 2)
Кампилобактериялар гентамицинге, хлорамфениколға, канамицинге, фуразолидонға, солафурге төзімсіз.
Сурет 2. Campylobacter jejuni.
2. 3 Ірі қара малдың кампилобактериоз ауруының эпиозоотологиялық мәліметтер
Ірі қара малдың кампилобактериоз ауруының қоздырушысы инфекцияның көзі - жұққан өгіз-өндіруші. Оларда микроб өмір бойы препуциалды қапта, ұрық безінде, шылауда сақталады және шәуетпен, препуциалды шырышпен және қуық алды секретпен бөлінеді. Ауру сиырлар да қауіп төндіреді. Олардан кампилобактерияларды 3-10 ай бойы жыныс мүшелерден ағулармен, несеппен және сүтпен, ал аборт кезінде түсік төлмен, төлдің қабықпен, сумен бөледі.
Инфекциясы қоздырушысы табиғи шағылыстыру және қолдан ұрықтандыру кезінде жыныс жолымен беріледі. Кампилобактериялар сиырдың қынапқа микробтармен ластанған төсеніш арқылы енуі мүмкін. Қоздырушының таратушы көздері - залалсыздандырылмаған акушерлік құрал-жабдықтар, қызмет көрсетуші персоналдардың бөлінділермен ластанған киімдер.
Кампилобактериялардың таратушылар масалар болу мүмкін.
Аурудан таза шаруашылыққа ауру қоздырушысы жұққан жануарлар әкелгенде немесе сиырды қолдан ұрықтандыру кезінде ауыраған өгіздердің шәуетті қолданағанда кіреді.
Аурудан таза емес табындарда ірі қара малдардың ауру қоздырушы 3 түрі қатысуы мүмкін. Олар: C. f. ssp. veneralis, C. f. ssp. fetus (intestinalis), C. jejuni. 2-10 күннен 3, 5 ай жасқа дейінгі бұзауларда C. jejuni жиі, ал C. f. ssp. fetus сирек білінеді. Сиырларда және өгіздерде барлық үш түрін ажыратады. Ірі қара малдың екінші және үшінші түрлермен жүғуы келесі факторларға байланысты: табиғатта кең таралған, көптеген жануарлар таратушы болып келеді, ветеринарлық саниатарлық іс-шараларды жеткіліксіз жүргізуі.
2. 4 Ірі қара малдың кампилобактериоз ауруының өтуі мен белгілері
... жалғасы- Іс жүргізу
- Автоматтандыру, Техника
- Алғашқы әскери дайындық
- Астрономия
- Ауыл шаруашылығы
- Банк ісі
- Бизнесті бағалау
- Биология
- Бухгалтерлік іс
- Валеология
- Ветеринария
- География
- Геология, Геофизика, Геодезия
- Дін
- Ет, сүт, шарап өнімдері
- Жалпы тарих
- Жер кадастрі, Жылжымайтын мүлік
- Журналистика
- Информатика
- Кеден ісі
- Маркетинг
- Математика, Геометрия
- Медицина
- Мемлекеттік басқару
- Менеджмент
- Мұнай, Газ
- Мұрағат ісі
- Мәдениеттану
- ОБЖ (Основы безопасности жизнедеятельности)
- Педагогика
- Полиграфия
- Психология
- Салық
- Саясаттану
- Сақтандыру
- Сертификаттау, стандарттау
- Социология, Демография
- Спорт
- Статистика
- Тілтану, Филология
- Тарихи тұлғалар
- Тау-кен ісі
- Транспорт
- Туризм
- Физика
- Философия
- Халықаралық қатынастар
- Химия
- Экология, Қоршаған ортаны қорғау
- Экономика
- Экономикалық география
- Электротехника
- Қазақстан тарихы
- Қаржы
- Құрылыс
- Құқық, Криминалистика
- Әдебиет
- Өнер, музыка
- Өнеркәсіп, Өндіріс
Қазақ тілінде жазылған рефераттар, курстық жұмыстар, дипломдық жұмыстар бойынша біздің қор #1 болып табылады.



Ақпарат
Қосымша
Email: info@stud.kz